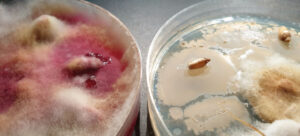
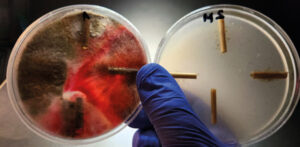
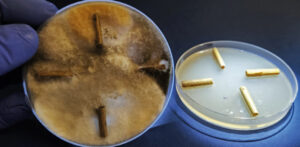
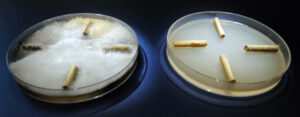
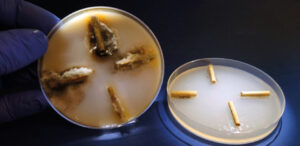
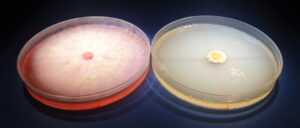
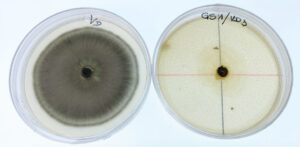
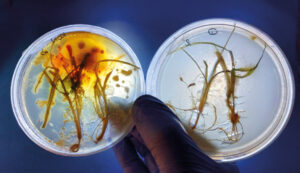
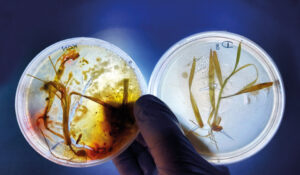
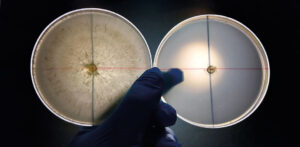
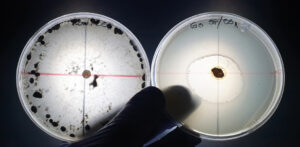

Bakto G-STOP – najlepszy standard preparatu biologicznego

Historia badań
Badania nad środkami biologicznymi w mojej pracowni rozpoczęły się prawie 10 lat temu. Dysponując dostępem do laboratorium mikrobiologicznego, wyposażonego w zaawansowany sprzęt taki jak: komory laminarne, cieplarki, wytrząsarki, autoklawy, a także metodykami badań in vitro i in vivo uruchomiłem procedury badań środków, zaliczanych do środków biologicznych, otrzymanych od rożnych dostawców pochodzących z Litwy, Ukrainy, Hiszpanii, Włoch oraz Polski. Początki nie były optymistyczne. Część środków dostarczonych było z martwą zawartością lub były po prostu nieaktywnych biologicznie. Niektórzy dostawcy forsowali stosowanie takich dawek środków, aby były one akceptowalne rynkowo, jednocześnie oczekując obiecujących wyników. Przykładów jest sporo. Zdarzało się, że inne rekomendacje były na etykiecie, inne rekomendował producent, jeszcze inne dystrybutor w Polsce, a co innego polecali doradcy dystrybutora. Przełomem okazał się jeden środek zastosowany w formie zaprawy do nasion. Ziarno nim zaprawione zostało wyłożone na neutralne podłoża w układzie zegarowym. Na środek szalki Petriego wszczepiono korkoborem korek infekcyjny jednego z gatunków Fusarium.
W ciągu kilku dni patogen umieszczony na środek 9 centymetrowej szalki rozrósł się do jej brzegów. Wyjątek stanowiła niewielka przestrzeń wokół zaprawionych środkiem biologicznym ziarniaków pszenicy. Wokół nich tworzyły się nieprzerośnięte prze grzybnię kręgi, wynoszące około 10-13 milimetrów średnicy, świadczące o reakcji obronnej przed kolonizacją grzyba. W strefie korzeni zarodkowych pojawiła się mleczna substancja, która nie dopuszczała do przerostu patogena z zewnątrz. Opublikowane zdjęcia wzbudziły zainteresowanie środowiska naukowego oraz producentów środków biologicznych. Niestety, w porównaniu do środków z grupy zapraw syntetycznych, wyglądało to jeszcze bardzo słabo. Dostarczane kolejne generacje biologicznych środków różnych dostawców przynosiły znacznie lepsze efekty. Tak zwany „efekt halo”, czyli przestrzeń wokół nasion była coraz to większa, co budziło coraz więcej emocji. Cały czas efekt nie był taki sam jak po zastosowaniu dobrej jakości chemicznej zaprawy.

Kontrola vs Bakto G-STOP. Środki biologiczne na martwej materii organicznej. Fot. dr inż. Andrzej Brachaczek

Aż wreszcie do badań trafił Bakto G-STOP – środek biologiczny polskiej produkcji oparty na Bacillus spp.. Kilka lat temu potwierdziliśmy w badaniach mikrobiologicznych, że środek ten daje podobną ochronę nasion jak zaprawy chemiczne, czasami lepszą i długotrwałą. Dzisiaj, kiedy Bakto G-STOP jest szeroko stosowany w gospodarstwach, zarówno konwencjonalnych jak i ekologicznych, wiemy że jest również silnym środkiem stymulującym, wpływającym na plon. W warunkach dużych powierzchni zasianych materiałem siewnym pokrytym Bakto G-STOP praktycznie można uzyskać około 1 tony więcej.
Badania in vitro
Bardzo dobre wyniki badań nad zastosowaniem Bakto G-STOP skłoniło mnie do głębszych badań typu in vitro. Do podłoża wprowadzany był Bakto G-STOP w stężeniach polowych, 1 ppm, 10 ppm, 30 ppm. Na środku szalki umieszczane były konkretne, zdefiniowane patogeny. Wyniki okazały się zaskakująco dobre. Jego aktywność biologiczna była wyraźnie widoczna, podobnie jak rozwijające się w pożywce kolonie
w postaci zatopionych przecinków lub dysków widocznych w niskich stężeniach gołym okiem.
Aplikacje polowe
Pozytywne wynik badań skłoniły do uruchomienia aplikacji polowych w różnych uprawach. Zdefiniowane zostały najlepsze pozycjoningi techniczne środka, które w części wymienione są na załączonym zdjęciu.
Zaprawianie
Bakto G-STOP jako zaprawa może być stosowany samodzielnie, ale też można mieszać środek z zaprawami chemicznymi. Zaprawiając nasiona, trzeba szczególną uwagę zwrócić na pokrycie cieczą roboczą. Urządzenia zaprawiające powinny być ustawione na możliwie małą wydajność i możliwą dużą dokładność zaprawiania. Wsypując zaprawiony materiał siewny do worka np. typu big-bag nie należy szczelnie go zamykać od razu, ani sztaplować jeden na drugim. W sytuacji bezpośredniego wykorzystania do siewu można zwiększyć ilość wody do zaprawy
Aplikacje polowe
Nie wykazano, aby Bakto G-STOP ulegał łatwej kontaminacji po otwarciu butelki. Nie wykazano także w opakowaniach obecności grzybów pleśniowych.
Odporność na działanie czynników fizycznych
Wbrew stereotypowym opiniom Bakto G-STOP jako preparat biologiczny nie jest wrażliwy na wyższe temperatury, ciśnienie robocze opryskiwaczy czy promieniowanie UV – prawdopodobnie dzięki obecności form przetrwalnikowych pożytecznych mikroorganizmów.
Podsumowanie
Bakto G-STOP przyniósł przełom w stosowaniu środków biologicznych. Do chwili obecnej stosowany jest
w badaniach innych środków jako środek referencyjny
i praktycznie nie ma sobie równych. Kierowanie się rekomendacjami opartymi na badaniach, pozwala uzyskać najlepsze
z możliwych efekty.

Kontrola vs Bakto G-STOP. Środki biologiczne na znekronozowanej tkance roślinnej. Fot. dr inż. Andrzej Brachaczek

Informacja prawna
Preparat Bakto G-STOP nie jest środkiem ochrony roślin w rozumieniu prawa i nie może być stosowany jako taki. Artykuł jest informacją z badań nad nim i nie stanowi rekomendacji do bezpośredniego stosowania do ograniczania i zwalczania patogenów.
Zgodnie z etykietą instrukcją stosowania Bakto G-STOP jest: mikrobiologicznym preparatem wspomagającym prawidłowy rozwój roślin.
Mikroorganizmy zawarte w produkcie wykazują dwukierunkowe działanie:
- Zasiedlają system korzeniowy, łodygi i liście tworząc barierę mikrobiologiczną ograniczającą rozwój patogenów, tzw. efekt „zajętego krzesła”.
- Wytwarzają metabolity, fitohormony oraz witaminy, które stymulują wzrost oraz plonowanie roślin.

Kontrola vs Bakto G-STOP. Fot. dr inż. Andrzej Brachaczek

dr inż. Andrzej Brachaczek, Dyrektor ds. Badań i Rozwoju, Innvigo




